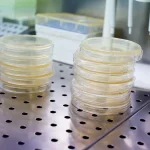
La Fe y el Clínic inician un ensayo clínico pionero con una CAR-T dirigida a leucemias agudas

La Unidad de Terapias Avanzadas del Hospital Universitari i Politècnic La Fe ha recibido la autorización de la Agencia Española de Medicamentos y Productos Sanitarios (Aemps) para la producción de medicamentos de terapia génica, por lo que podrá fabricar sus propias terapias celulares y génicas, como son los tratamientos CAR-T.
La directora general de Farmacia, Elena Gras, ha realizado una visita al Hospital La Fe, junto al responsable de la Oficina Autonómica de Medicina Predictiva, Personalizada y Terapias Avanzadas de la Comunitat Valenciana, Juan Eduardo Megías, y el gerente del Hospital La Fe, José Luis Poveda.
En este sentido, según ha destacado Elena Gras “con esta certificación, La Fe se convierte en el primer hospital de la Comunitat Valenciana autorizado para la producción de una terapia génica, un paso decisivo para la autonomía y el liderazgo de la sanidad pública valenciana en medicina de precisión”. Se trata de un avance decisivo para la Comunitat Valenciana, ya que consolida al Hospital La Fe como referente nacional en terapias avanzadas, producción de CAR-T y medicina de precisión.
“Esta autorización de la Aemps confirma objetivamente que el Hospital La Fe dispone de la capacidad científica, tecnológica y regulatoria necesaria para liderar la producción y el desarrollo de terapias avanzadas en España”, ha señalado la directora general de Farmacia, Elena Gras, quien ha recordado que la Conselleria ha recurrido la adjudicación de la sede de Certera a Madrid y Barcelona. “La Comunitat Valenciana presentó una candidatura sólida y solvente, y este reconocimiento refuerza nuestra posición como emplazamiento estratégico para asumir un papel estructural dentro del Consorcio”.
Asimismo, ha añadido que “La Fe, como único centro valenciano integrado en Certera, es ya un nodo clínico e industrial altamente especializado. Vamos a seguir defendiendo ante el Ministerio de Ciencia, Innovación y Universidades que la Comunitat Valenciana merece el reconocimiento que le corresponde en el mapa estatal de innovación biomédica”.
De hecho, esta acreditación valida que las instalaciones, el personal y los procesos de producción del hospital cumplen con las estrictas Normas de Correcta Fabricación (NCF o GMP, por sus siglas en inglés), garantizando la máxima calidad y seguridad de los tratamientos que se administrarán a los pacientes. Además, certifica que La Fe es capaz de producir CAR-T al mismo nivel de calidad que el Clínic, que es el centro con mayor experiencia en España y uno de los pioneros en Europa.
Este hito representa un salto cualitativo para la sanidad valenciana que permite al Hospital La Fe no solo administrar, sino también fabricar sus propias terapias celulares y génicas, como los tratamientos CAR-T, reduciendo la dependencia de producción externa y acortando los tiempos de espera para pacientes con enfermedades graves, como leucemias o linfomas.
Hasta el momento la Unidad de Terapias Avanzadas contaba con la autorización de la Aemps para la producción de Linfocitos T diferenciados alogénicos de sangre periférica no expandidos INFgamma+ tras estimulación con péptido viral, siendo centro productor dentro del primer ensayo con terapia celular antiviral elaborada íntegramente en España en colaboración con el Hospital Vall d´Hebron Instituto de Oncología (VHIO), y con el Banc de Sang i Teixits de Barcelona (BST).
El alcance de esta nueva autorización permitirá al Hospital La Fe iniciar un ensayo clínico de Fase I/IIa con GYA01. Este ensayo evaluará GYA01 en pacientes con leucemia mieloide aguda (LMA) o leucemia linfoblástica aguda de células T (LLA-T) en recaída o refractarios (R/R), dos enfermedades asociadas a un pronóstico desfavorable y con opciones terapéuticas limitadas en este contexto clínico. Este CAR-T será una terapia puente antes del trasplante hematopoyético, un enfoque completamente novedoso frente a otros CAR-T. El objetivo es lograr eliminar por completo las células tumorales para evitar futuras recaídas tras el trasplante.
Finalmente, la directora general ha destacado la relevancia de esta unidad estratégica, “como único centro valenciano incluido en el Consorcio Estatal en Red para el desarrollo de Medicamentos de Terapias Avanzadas (Certera), que nos posiciona como centro de referencia para el desarrollo y la producción de estos medicamentos que contribuyen a ofrecer oportunidades para enfermedades que carecen de tratamientos eficaces”.

César Hernández, director general de Cartera y Farmacia del Ministerio de Sanidad:
César Hernández, director general de Cartera y Farmacia del Ministerio de Sanidad:  Kilian Sánchez, secretario de Sanidad del PSOE y portavoz de la Comisión de Sanidad del Senado.:
Kilian Sánchez, secretario de Sanidad del PSOE y portavoz de la Comisión de Sanidad del Senado.:  Rocío Hernández, consejera de Salud de Andalucía:
Rocío Hernández, consejera de Salud de Andalucía:  Nicolás González Casares, eurodiputado de Socialistas & Demócratas (S&D - PSOE):
Nicolás González Casares, eurodiputado de Socialistas & Demócratas (S&D - PSOE):  Juan José Pedreño, consejero de Salud de Murcia:
Juan José Pedreño, consejero de Salud de Murcia: